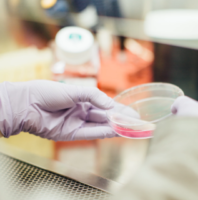

Drug Fact Sheet: Opioids and Opiates
Posted by CDR Help Desk on Sep 13, 2018 in Blog | 0 comments
With the ongoing opioid crisis being felt in Toronto, Vancouver, and most towns and cities across North America, many could use a refresher on what opioids are and why they affect the human body so strongly. In the past, opioid referred only to synthetic opiates, drugs that were chemically created to mimic opium. Opiates referred only to drugs derived from opium that is naturally occurring in the poppy plant. However, most medical professionals and the media now use opioid as the general term.
With the ongoing opioid crisis being felt in Toronto, Vancouver, and most towns and cities across North America, many could use a refresher on what opioids are and why they affect the human body so strongly. In the past, opioid referred only to synthetic opiates, drugs that were chemically created to mimic opium. Opiates referred only to drugs derived from opium that is naturally occurring in the poppy plant. However, most medical professionals and the media now use opioid as the general term.
What is an Opioid?
“An opioid is any agent that binds to opioid receptors (protein molecules located on the membranes of some nerve cells) found principally in the central nervous system and gastrointestinal tract and elicits a response.” Morphine, methadone, oxycodone, and heroin are examples of opioids you may be familiar with. There are four classes of opioids:
- Endogenous opioids. These naturally occur in the body as endorphins.
- Opium alkaloids. Examples are morphine and codeine.
- Semi-synthetic opioids, like heroin and oxycodone.
- Fully synthetic opioids. For example, methadone.
How do Opioids Affect the Body?
The human brain has opioid receptors, so when opioids are injested they attach to those receptors in the brain. The effects include dulling pain, slowed breathing, and a general calm feeling. Naturally occurring opioids like endorphins cannot cause a person to overdose. When opioids are injested they can give the user feelings of intense euphoria. A higher dose can depress the breathing to the point of overdose and death. Respiratory depression is the main cause of death in fatal opioid overdoses. This is especially concerning when opioids are taken in conjunction with other depressants like alcohol and two non-lethal doses combined can lead to a fatal overdose.
What if I Have a Problem with Opioids?
If it is hard for you to restrict your recreational use of opioids, or feel you are reliant on prescription opioids, there are lots of ways to get help. The federal government has made it easier across the provinces to access drugs like methadone and Suboxone. These drugs allow you to come off of opioids with minimal withdrawal sickness symptoms and come with a plan to eventually taper off of the maintenance medication too. To learn more about methadone and Suboxone read our article here. Our database of drug and alcohol rehabs in Canada makes note of the facilities that offer medical maintenance programs. If you need help navigating the site or have more questions, call or email our specialist here.
References:
The post Drug Fact Sheet: Opioids and Opiates appeared first on Canada Drug Rehab.



